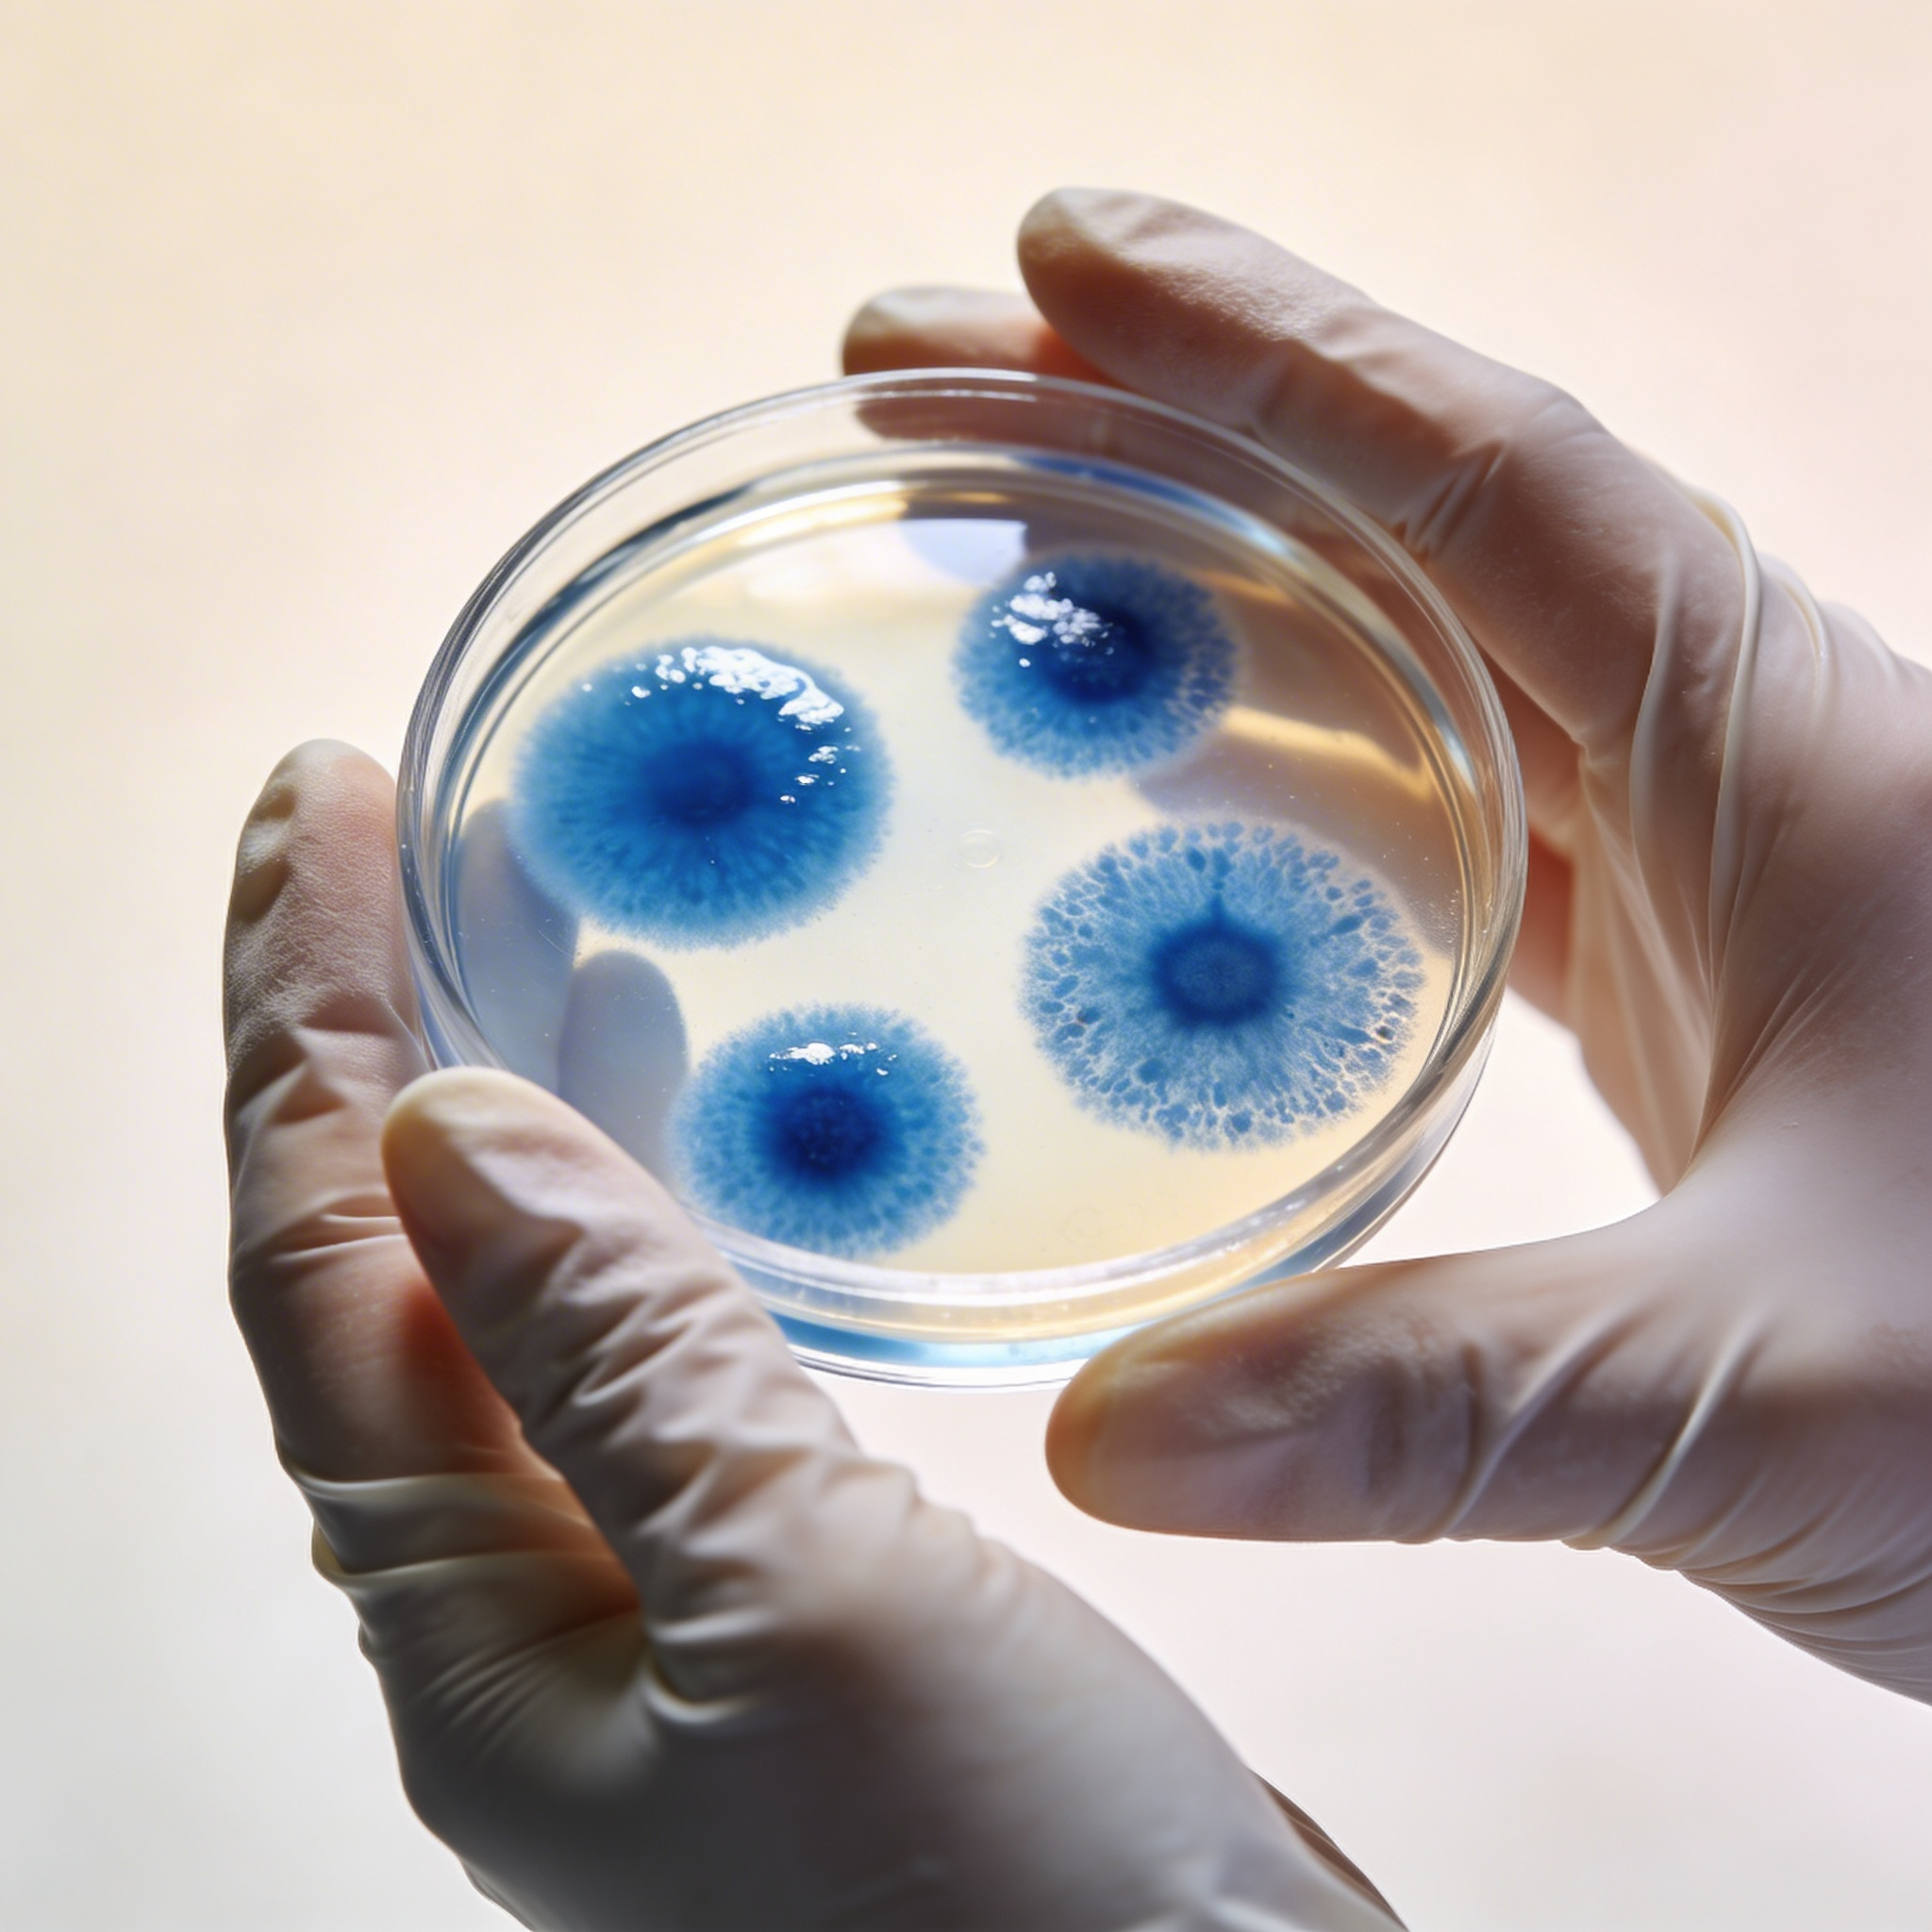

Danone Biotics
Danone | Research & Innovation
Biotics make the invisible visible.
Our role in this campaign is basically to turn what you can’t see — microbial communities, molecular signals, and hidden interactions—into insights we can measure, map, and actually use. It’s rooted in real science
(microbes are mostly invisible, but they have a huge impact), and it speaks
to what this community does every day: using modern tools to uncover patterns that shape health, ecosystems, and industry.

Glass, transparency and light are used
as connective elements:
linking science, nature and the body.
Mood: modern, calm, confident.


Equipe:
Diretor de Criação: Guilherme Vermelho
Direção de arte & conceito: Yasmin
Design System/ilustrações: Willian Balbueno
Candy Shop Ag.

